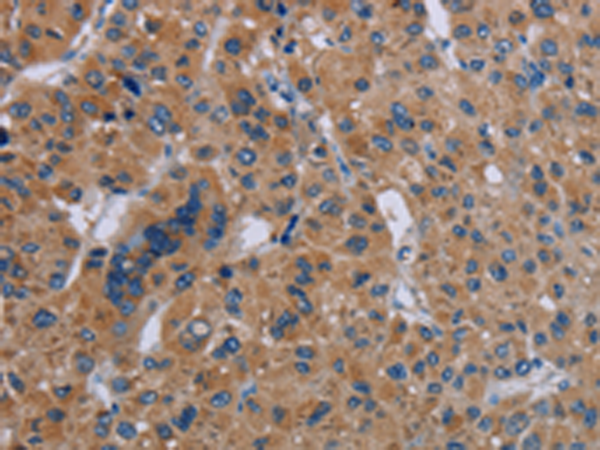
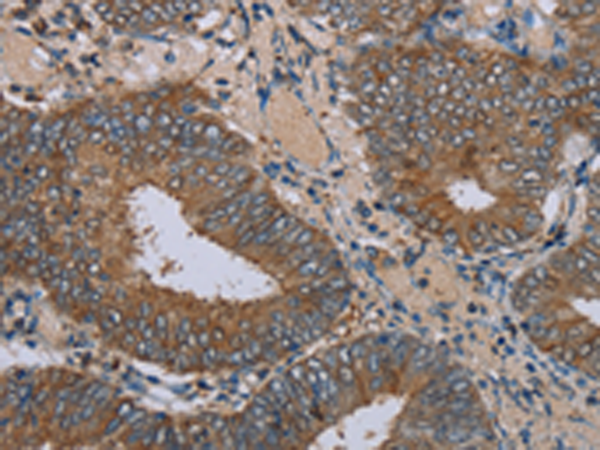
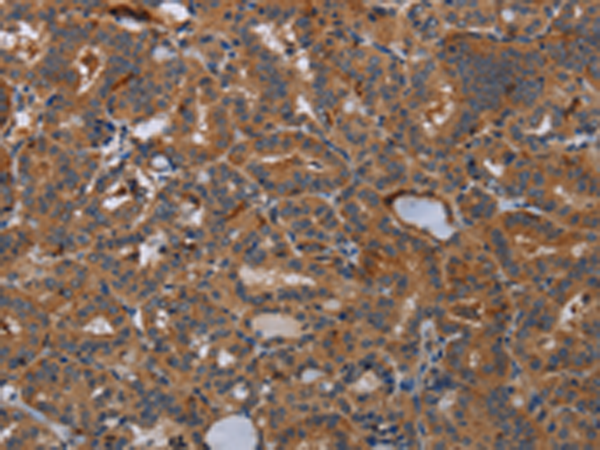
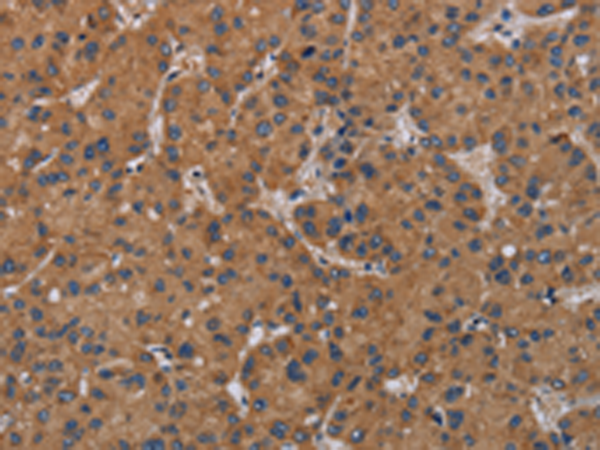

-
分类: 科研抗体货号: P08437别名: CRL1; TCCR; WSX1; IL27R; IL-27RA; zcytor1应用: WB,IHC反应种属: Human
-
分类: 科研抗体货号: P08449别名: HL1; LFR; HL-1; INTL; ITLN; hIntL; omentin应用: WB反应种属: Human, Mouse
-
分类: 科研抗体货号: P08430别名: NOV; NOVh; IBP-9; IGFBP9; IGFBP-9应用: WB,IHC反应种属: Human, Mouse, Rat
-
分类: 科研抗体货号: P08436别名: CRF2X; CRF2-10; CRF2-S1; IL-22BP; IL-22RA2; ZCYTOR16; IL-22R-alpha-2应用: WB,IHC反应种属: Human, Mouse
-
分类: 科研抗体货号: P08447别名: IFI1; IRGM1; LRG47; LRG-47应用: WB,IHC反应种属: Human
-
分类: 科研抗体货号: P08429别名: PC4; TIS7应用: IHC反应种属: Human, Mouse, Rat
-
分类: 科研抗体货号: P08470别名: CHL1; KRG2; WABS; CHLR1应用: IHC反应种属: Human
-
分类: 科研抗体货号: P08445别名: CD103; HUMINAE应用: IHC反应种属: Human
-
分类: 科研抗体货号: P08428别名: MX; MxA; IFI78; IFI-78K应用: WB反应种属: Human
-
分类: 科研抗体货号: P08469别名: KLKL4; KLK-L4应用: IHC反应种属: Human

鄂公网安备42018502007531号
鄂公网安备42018502007531号

